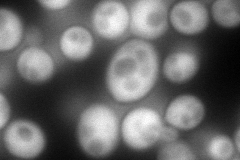
YKL084W
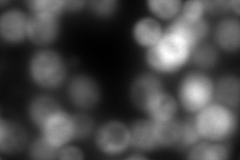
YKL084W
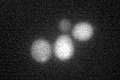
YKL084W

View description
Mitochondrial intermembrane space protein, first component of a pathway mediating assembly of small TIM (Translocase of the Inner Membrane) complexes which escort hydrophobic inner membrane proteins en route to the TIM22 complex
Localization:
Intensity:
Fold change:
Significance:
-
C’ GFP library in SD

cytosol21.55 -
N' NOP1pr-GFP in SD
cytosol216.985 -
N' TEF2pr-mCherry in SD
cytosol0 -
N' NATIVEpr-GFP in SD

cytosol30.8413 -
N' TEF2pr-VC and Cyto-VN in SD

cytosol65.1056 -
C’ GFP library in SD+DTT
cytosol20.360.94No -
C’ GFP library in SD+H2O2

cytosol24.531.13No -
C’ GFP library in Starvation Media

cytosol20.10.93No -
C’ GFP library on the background of Pup2-DaMP

cytosol -
C’ GFP library on the background of CCT mutant

cytosol17.96730.833568No
